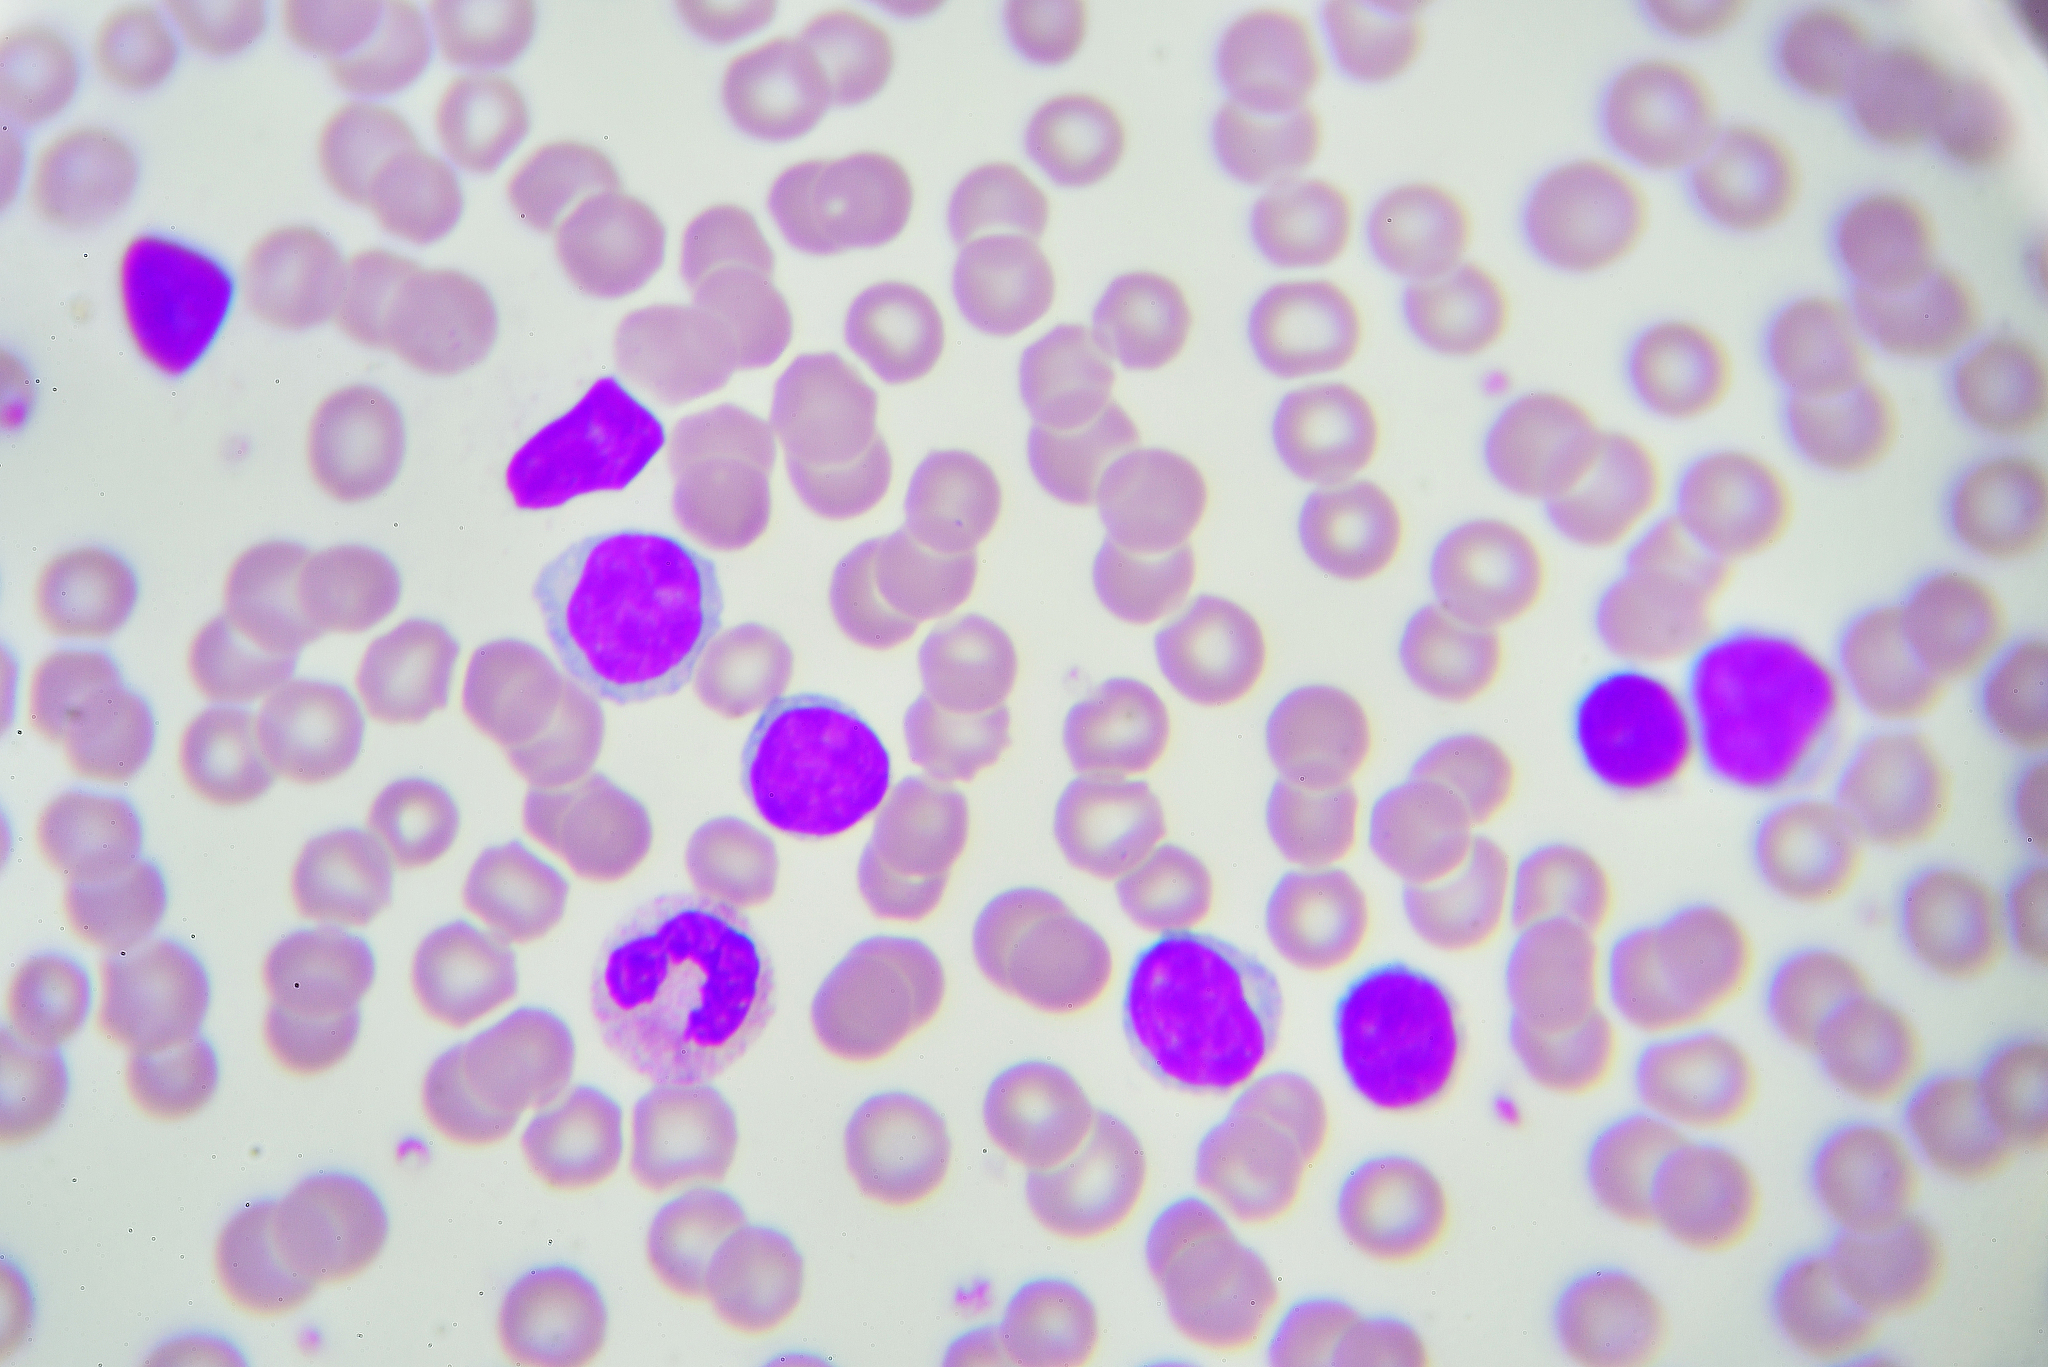
免疫组织化学染色

免疫组织化学染色
免疫组织化学染色是一种基于免疫学原理的组织染色方法,用于检测和定位组织中特定抗原的存在和分布。该方法利用抗体与目标抗原的特异性结合,通过染色反应显示出目标抗原的位置和数量。
免疫组织化学染色的步骤包括:
- 取得待检测的组织切片。
- 对组织切片进行脱脂和去水处理,以便后续步骤的抗体渗透。
- 应用特异性的一抗体,该抗体能够与目标抗原结合。一抗体可以是单克隆抗体或多克隆抗体。
- 清洗切片以去除未结合的一抗体,并防止非特异性结合。
- 应用与一抗体结合的二抗体,二抗体通常是标记有染色物质(如荧光标记或酶标记)的抗动物的抗体。
- 再次清洗切片,以去除未结合的二抗体。
- 根据染色物质的类型,可以进行荧光显微镜观察或酶标染色反应。荧光显微镜观察可以直接显示出目标抗原的位置和分布;酶标染色反应则通过酶催化反应产生有色产物,从而显示出目标抗原的位置和分布。
- 最后,对染色后的组织切片进行显微镜观察和分析。
免疫组织化学染色方法可以用于研究抗体的分布和表达,检测疾病标记物,评估药物治疗效果等。
原文地址: https://www.cveoy.top/t/topic/iGdZ 著作权归作者所有。请勿转载和采集!